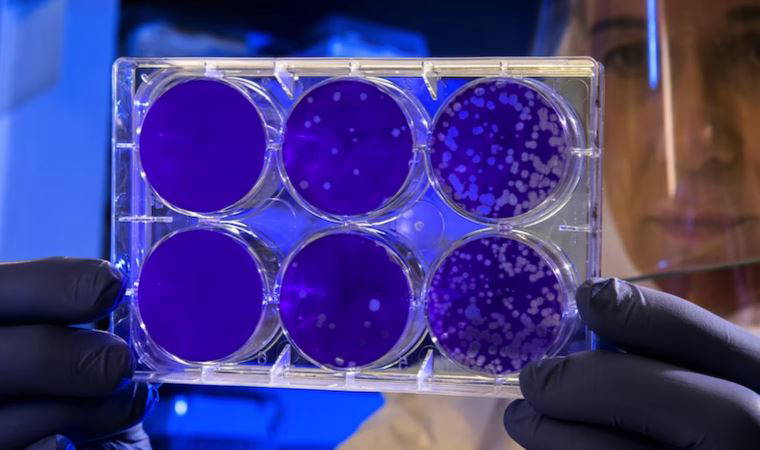
Kanserle savaşta yeni yöntem: Genetiği değiştirilmiş bakteriler

Yeni keşfedilen doğal bileşik yaşlanan güçleri 1 aydan kısa sürede gençleştirebiliyor
Yaşlanan hücreleri eski haline döndürmek ya da gençleştirmek yıllardır bilim dünyasının peşinde koştuğu bir hayal gibi dursa da gerçekleştirmeye oldukça yaklaştı.
Yeni keşfedilen doğal bileşik yaşlanan güçleri 1 aydan kısa sürede gençleştirebiliyor
Yaşlanan hücreleri eski haline döndürmek ya da gençleştirmek yıllardır bilim dünyasının peşinde koştuğu bir hayal gibi dursa da gerçekleştirmeye oldukça yaklaştı.
 Kanser tedavisi gören Ediz Hun'dan sevindiren haber!
Yeşilçam'ın usta ismi Ediz Hun sağlık durumu hakkında açıklamalarda bulundu.
Kanser tedavisi gören Ediz Hun'dan sevindiren haber!
Yeşilçam'ın usta ismi Ediz Hun sağlık durumu hakkında açıklamalarda bulundu.
 Uzmanı açıkladı: Kanserden korunmanın yolları!
Uzmanlar, kronik stresin, yanlış beslemenin ve obezitenin kanser türlerine adeta davetiye çıkardığını ifade ederek, özellikle yüksek kalorili, düşük lifli ve işlenmiş gıdalardan uzak durulmasını tavsiye etti.
Uzmanı açıkladı: Kanserden korunmanın yolları!
Uzmanlar, kronik stresin, yanlış beslemenin ve obezitenin kanser türlerine adeta davetiye çıkardığını ifade ederek, özellikle yüksek kalorili, düşük lifli ve işlenmiş gıdalardan uzak durulmasını tavsiye etti.
 Kanseri tedavisinde çığır açan keşif: CART-T hücreleri görülmemiş başarı sağladı
Bilim insanları, genetik mühendislik yoluyla geliştirilen CAR T-hücre tedavisinin, ölümcül bir sinir tümörü türü olan nöroblastoma karşısında 18 yıldır etkili olduğunu tespit etti. Bu, CAR T-hücre tedavisiyle sağlanan en uzun remisyon olarak kayıtlara geçti. Uzmanlar, bu vakayı kanser tedavisinde çığır açabilecek bir gelişme olarak değerlendiriyor.
Kanseri tedavisinde çığır açan keşif: CART-T hücreleri görülmemiş başarı sağladı
Bilim insanları, genetik mühendislik yoluyla geliştirilen CAR T-hücre tedavisinin, ölümcül bir sinir tümörü türü olan nöroblastoma karşısında 18 yıldır etkili olduğunu tespit etti. Bu, CAR T-hücre tedavisiyle sağlanan en uzun remisyon olarak kayıtlara geçti. Uzmanlar, bu vakayı kanser tedavisinde çığır açabilecek bir gelişme olarak değerlendiriyor.
 Kanser için alternatif tedaviler nedir, işe yarıyorlar mı?
Kanser tedavisi ve rehabilitasyonu için çalışan vakıfların çoğu, alternatif yöntemlerin kanseri tedavi ettiğine ya da iyileştirdiğine dair tıbbi kanıt olmadığını söylüyor. Peki bu alternatif tedaviler neler ve başvuranların sayısı neden artıyor?
Kanser için alternatif tedaviler nedir, işe yarıyorlar mı?
Kanser tedavisi ve rehabilitasyonu için çalışan vakıfların çoğu, alternatif yöntemlerin kanseri tedavi ettiğine ya da iyileştirdiğine dair tıbbi kanıt olmadığını söylüyor. Peki bu alternatif tedaviler neler ve başvuranların sayısı neden artıyor?
 Dünya genelinde en yaygın sağlık sorunlarından biri... Kanser riskini azaltan 10 önemli alışkanlık!
Kanser, modern çağın en korkulan hastalıklarından biri olarak her yıl milyonlarca insanı etkiliyor. Ancak bilimsel araştırmalar, kanser riskini büyük ölçüde azaltmanın mümkün olduğunu gösteriyor. İşte kanser riskini azaltmanıza yardımcı olacak 10 önemli alışkanlık...
Dünya genelinde en yaygın sağlık sorunlarından biri... Kanser riskini azaltan 10 önemli alışkanlık!
Kanser, modern çağın en korkulan hastalıklarından biri olarak her yıl milyonlarca insanı etkiliyor. Ancak bilimsel araştırmalar, kanser riskini büyük ölçüde azaltmanın mümkün olduğunu gösteriyor. İşte kanser riskini azaltmanıza yardımcı olacak 10 önemli alışkanlık...
 Kanser tedavisinde yeni umut: 'Tırtıl Mantarı' virüsleri yok edebilir!
Bilimsel araştırmaların en fazla yoğunlaştığı hastalıklardan biri olan kanser için yeni bir keşif gündeme geldi. Bilim insanları 'Tırtıl Mantarı' kullanarak kanser hücrelerini bozabilmenin yolunu buldu.
Kanser tedavisinde yeni umut: 'Tırtıl Mantarı' virüsleri yok edebilir!
Bilimsel araştırmaların en fazla yoğunlaştığı hastalıklardan biri olan kanser için yeni bir keşif gündeme geldi. Bilim insanları 'Tırtıl Mantarı' kullanarak kanser hücrelerini bozabilmenin yolunu buldu.
 Yapay zekayla kanser hücreleri saniyeler içinde tespit edilebiliyor
Yapay zeka teknolojilerinin kullanımının artmasıyla kanser hücrelerinin daha erken ve kısa sürede tespit edilmesi mümkün hale geliyor.
Yapay zekayla kanser hücreleri saniyeler içinde tespit edilebiliyor
Yapay zeka teknolojilerinin kullanımının artmasıyla kanser hücrelerinin daha erken ve kısa sürede tespit edilmesi mümkün hale geliyor.
 Her 19 kişiden 1’i prostat kanseri riski taşıyor
Bilecik İl Sağlık Müdürü Dr. Ferhat Damkacı, dünyada her 19 kişiden 1’i prostat kanseri riskinde olduğunu söyleyerek, "Erkeklerin 50 yaşından itibaren, birinci derece akrabasında prostat kanseri görülenlerin ise 40 yaşından itibaren üroloji uzmanına düzenli olarak muayene olması gerekir" dedi.
Her 19 kişiden 1’i prostat kanseri riski taşıyor
Bilecik İl Sağlık Müdürü Dr. Ferhat Damkacı, dünyada her 19 kişiden 1’i prostat kanseri riskinde olduğunu söyleyerek, "Erkeklerin 50 yaşından itibaren, birinci derece akrabasında prostat kanseri görülenlerin ise 40 yaşından itibaren üroloji uzmanına düzenli olarak muayene olması gerekir" dedi.
 Yapay zeka aracıyla kanser hücreleri nano ölçekte tespit edebiliyor
Çin ve İspanya'dan araştırmacılar, "AINU (Hücre çekirdeği yapay zekası)" isimli yeni yapay zeka aracı yardımıyla kanser hücreleri ve viral enfeksiyonların nano ölçekte tespit edilebildiğini belirtti.
Yapay zeka aracıyla kanser hücreleri nano ölçekte tespit edebiliyor
Çin ve İspanya'dan araştırmacılar, "AINU (Hücre çekirdeği yapay zekası)" isimli yeni yapay zeka aracı yardımıyla kanser hücreleri ve viral enfeksiyonların nano ölçekte tespit edilebildiğini belirtti.
 Sağlığınıza kalkan olun: Kanserle mücadele eden 4 güçlü besin...
Kanserle savaşan faydalı besinleri tüketmek, hastalık riskini hafifleterek kanser savıcı bir etki gösterir. Peki, sağlığınıza kalkan olacak gıdalar nelerdir? İşte, kanserle mücadele eden 4 güçlü besin...
Sağlığınıza kalkan olun: Kanserle mücadele eden 4 güçlü besin...
Kanserle savaşan faydalı besinleri tüketmek, hastalık riskini hafifleterek kanser savıcı bir etki gösterir. Peki, sağlığınıza kalkan olacak gıdalar nelerdir? İşte, kanserle mücadele eden 4 güçlü besin...
 Yüz yıllık reçete: Bir kaşığı kansere meydan okuyor
Maden suyu ve sirke karışımı, yüzyıllardır sağlık için kullanılan basit ama etkili bir reçetedir. Sindirim sistemini desteklemekten kansere karşı koruyucu etkilerine kadar birçok faydası bulunan bu karışımı, günlük rutininize ekleyerek daha sağlıklı bir yaşam sürdürebilirsiniz.
Yüz yıllık reçete: Bir kaşığı kansere meydan okuyor
Maden suyu ve sirke karışımı, yüzyıllardır sağlık için kullanılan basit ama etkili bir reçetedir. Sindirim sistemini desteklemekten kansere karşı koruyucu etkilerine kadar birçok faydası bulunan bu karışımı, günlük rutininize ekleyerek daha sağlıklı bir yaşam sürdürebilirsiniz.
 'Tümörlerle mücadelenin anahtarı...'
Nature Immunology dergisinde yayınlanan bir çalışmada, vücudun farklı bölgelerinde kanseri "avlayan" beyaz kan hücrelerinin, yayılan tümörlerle mücadelenin anahtarı olabileceği tespit edildi.
'Tümörlerle mücadelenin anahtarı...'
Nature Immunology dergisinde yayınlanan bir çalışmada, vücudun farklı bölgelerinde kanseri "avlayan" beyaz kan hücrelerinin, yayılan tümörlerle mücadelenin anahtarı olabileceği tespit edildi.
 Uzmanından korkutan uyarı: 'Stres kansere neden olabilir'
Tıbbi Onkoloji Uzmanı Doç. Dr. Türkan Öztürk Topcu, uzun süreli stresin kansere neden olabileceğini söyledi. Topcu, nefes teknikleri, egzersiz, sağlıklı beslenme ve düzenli uyku gibi etkenlerin kanserden korunma noktasındaki önemine vurgu yaptı.
Uzmanından korkutan uyarı: 'Stres kansere neden olabilir'
Tıbbi Onkoloji Uzmanı Doç. Dr. Türkan Öztürk Topcu, uzun süreli stresin kansere neden olabileceğini söyledi. Topcu, nefes teknikleri, egzersiz, sağlıklı beslenme ve düzenli uyku gibi etkenlerin kanserden korunma noktasındaki önemine vurgu yaptı.
 'Çığır açan' akciğer kanseri aşısı geliştiriliyor
AstraZeneca Covid-19 aşısını yaratan benzer teknolojiyi kullanan araştırmacılar, kanser hücrelerini öldürmeyi amaçlayan LungVax aşısını geliştirmeye başladı.
'Çığır açan' akciğer kanseri aşısı geliştiriliyor
AstraZeneca Covid-19 aşısını yaratan benzer teknolojiyi kullanan araştırmacılar, kanser hücrelerini öldürmeyi amaçlayan LungVax aşısını geliştirmeye başladı.
 Prof. Dr. Derya Unutmaz'dan çok konuşulacak açıklama: 'Kanser 10-15 yıla tarih olacak'
ABD’deki Jackson Laboratuvarı Enstitüsü’nün baş araştırmacısı Prof. Dr. Derya Unutmaz, "Önümüzdeki 10-15 yıl içinde tedavisi olmayacak kanser kalmayacak diye düşünüyorum" dedi.
Prof. Dr. Derya Unutmaz'dan çok konuşulacak açıklama: 'Kanser 10-15 yıla tarih olacak'
ABD’deki Jackson Laboratuvarı Enstitüsü’nün baş araştırmacısı Prof. Dr. Derya Unutmaz, "Önümüzdeki 10-15 yıl içinde tedavisi olmayacak kanser kalmayacak diye düşünüyorum" dedi.
 Kanserle savaşta önemli keşif: Ameliyatsız yeni yöntem
Bilim insanları, kanser hücrelerini tespit etmek amacıyla kullanılan bir molekülün, kanser tedavisinde kullanabileceklerini keşfetti.
Kanserle savaşta önemli keşif: Ameliyatsız yeni yöntem
Bilim insanları, kanser hücrelerini tespit etmek amacıyla kullanılan bir molekülün, kanser tedavisinde kullanabileceklerini keşfetti.
 Suda kaynatmanız yeterli: Kanser tedavisinde çığır açtı!
Gelincikgiller ailesine ait olan turp, sofralarımıza lezzet katarak sadece damakları değil, aynı zamanda vücudu da koruyabilir. İşte turpun kansere olan bu faydalarını daha yakından inceleyelim.
Suda kaynatmanız yeterli: Kanser tedavisinde çığır açtı!
Gelincikgiller ailesine ait olan turp, sofralarımıza lezzet katarak sadece damakları değil, aynı zamanda vücudu da koruyabilir. İşte turpun kansere olan bu faydalarını daha yakından inceleyelim.
 Ultra işlenmiş gıdaların tüketimi mide ve bağırsak kanseri riskini arttırıyor
İngiltere’deki Bristol Üniversitesi ve Uluslararası Kanser Araştırma Ajansı (IARC) tarafından yapılan araştırmada, 450 bin 111 kişiden elde edilen veriler analiz edilerek, ultra işlenmiş gıdaların (UPF) tüketiminin üst solunum yolu ve sindirim sistemi kanseri riskini artırdığı tespit edildi.
Ultra işlenmiş gıdaların tüketimi mide ve bağırsak kanseri riskini arttırıyor
İngiltere’deki Bristol Üniversitesi ve Uluslararası Kanser Araştırma Ajansı (IARC) tarafından yapılan araştırmada, 450 bin 111 kişiden elde edilen veriler analiz edilerek, ultra işlenmiş gıdaların (UPF) tüketiminin üst solunum yolu ve sindirim sistemi kanseri riskini artırdığı tespit edildi.
 Onkoloji doktorları öneriyor! Bu mantar kanser hücresini yok ediyor
Kanser, hala büyük bir sağlık sorunu olarak karşımıza çıkıyor ve bu hastalığın tedavi ve önlenmesi için bilim insanları sürekli olarak yeni yöntemler arayışındalar. Son yıllarda, kanserle mücadelede doğal bitkisel çözümler ve takviyeler giderek daha fazla ilgi görüyor. Bunlardan biri de ölümsüzlük mantarı olarak bilinen Reishi mantarı...
Onkoloji doktorları öneriyor! Bu mantar kanser hücresini yok ediyor
Kanser, hala büyük bir sağlık sorunu olarak karşımıza çıkıyor ve bu hastalığın tedavi ve önlenmesi için bilim insanları sürekli olarak yeni yöntemler arayışındalar. Son yıllarda, kanserle mücadelede doğal bitkisel çözümler ve takviyeler giderek daha fazla ilgi görüyor. Bunlardan biri de ölümsüzlük mantarı olarak bilinen Reishi mantarı...
 Kanser önleyici eşek sütü hakkında her şey!
Anne sütüne en yakın besin değeriyle dikkat çeken eşek sütü, eski Mısır döneminden günümüze kadar faydaları nedeniyle ön plana çıkmış bir süt türüdür. Eşek sütünün faydaları nelerdir?
Kanser önleyici eşek sütü hakkında her şey!
Anne sütüne en yakın besin değeriyle dikkat çeken eşek sütü, eski Mısır döneminden günümüze kadar faydaları nedeniyle ön plana çıkmış bir süt türüdür. Eşek sütünün faydaları nelerdir?
 Kanser hücrelerini tespit etmek için bakteriler geliştirildi
Bilim insanları genetik mühendislikle kanser hücrelerini tespit için bakteri geliştirdi. Deneyleri başarılı oldu ancak teknoloji henüz kullanıma hazır değil.
Kanser hücrelerini tespit etmek için bakteriler geliştirildi
Bilim insanları genetik mühendislikle kanser hücrelerini tespit için bakteri geliştirdi. Deneyleri başarılı oldu ancak teknoloji henüz kullanıma hazır değil.
 Kanser hücrelerinin kendilerini yok etmesini sağlayacak yeni yöntem
İsrailli araştırmacıların kanser hücrelerinin kendi kendine toksin üretip yok olmalarını sağlayan bir yöntem geliştirdiğini açıklandı.
Kanser hücrelerinin kendilerini yok etmesini sağlayacak yeni yöntem
İsrailli araştırmacıların kanser hücrelerinin kendi kendine toksin üretip yok olmalarını sağlayan bir yöntem geliştirdiğini açıklandı.
 İlaçla tedavi edilemeyen kanser geni için tarihi buluş!
Yeni molekül kansere neden olan yaygın genin "ilaçla tedavi edilemeyen" RNA'sını parçalıyor. Bilim insanları bu geni 'Everest Dağı' geni olarak tanımlıyor.
İlaçla tedavi edilemeyen kanser geni için tarihi buluş!
Yeni molekül kansere neden olan yaygın genin "ilaçla tedavi edilemeyen" RNA'sını parçalıyor. Bilim insanları bu geni 'Everest Dağı' geni olarak tanımlıyor.
 Bilim insanları, kanserin bağışıklık sisteminden nasıl kaçındığını buldu
Yeni bir araştırma, kanser hücrelerinin, bağışıklık sistemi tarafından tespit edilmekten nasıl kaçındığını ortaya koydu. Araştırmanın detayları, Nature Communications dergisinde yayımlandı.
Bilim insanları, kanserin bağışıklık sisteminden nasıl kaçındığını buldu
Yeni bir araştırma, kanser hücrelerinin, bağışıklık sistemi tarafından tespit edilmekten nasıl kaçındığını ortaya koydu. Araştırmanın detayları, Nature Communications dergisinde yayımlandı.
 Stres kanserin tetikleyici faktörleri arasında
Çağımızın en önemli sağlık sorunu olan kansere karşı şuurlanmanın önemini anlatan Op. Dr. Mehmet Tekin, kansere neden olan risk faktörlerinden kaçınmanın, erken tanı ve erken dönemde tedavi ile kanserden korunmanın mümkün olduğunu söyledi.
Stres kanserin tetikleyici faktörleri arasında
Çağımızın en önemli sağlık sorunu olan kansere karşı şuurlanmanın önemini anlatan Op. Dr. Mehmet Tekin, kansere neden olan risk faktörlerinden kaçınmanın, erken tanı ve erken dönemde tedavi ile kanserden korunmanın mümkün olduğunu söyledi.
Kanserle savaşta yeni yöntem: Genetiği değiştirilmiş bakteriler
Kanserle savaşta umut veren yeni yöntem: Kanser hücrelerine gizlice sızarak bağışıklık sistemini harekete geçiren genetiği değiştirilmiş bakteriler.
Kanserle savaşta yeni yöntem: Genetiği değiştirilmiş bakteriler
Kanserle savaşta umut veren yeni yöntem: Kanser hücrelerine gizlice sızarak bağışıklık sistemini harekete geçiren genetiği değiştirilmiş bakteriler.
 Kanserde beslenme büyük önem taşıyor
Kanser tedavisi gören bir kişinin yediği gıdalara dikkat etmesi gerektiğini belirten uzmanlar, bu hastaların tedavi ve hastalığın etkilerinden dolayı kilo vermeye meyilli olduğunu söyledi.
Kanserde beslenme büyük önem taşıyor
Kanser tedavisi gören bir kişinin yediği gıdalara dikkat etmesi gerektiğini belirten uzmanlar, bu hastaların tedavi ve hastalığın etkilerinden dolayı kilo vermeye meyilli olduğunu söyledi.
 Kanser hücrelerini ameliyatsız tespit eden cihaz
Sidney Teknoloji Üniversitesi öncülüğündeki bir araştırma ekibi, kanser hücrelerinin kan örneklerinden tespit edilip analiz edilmesi için yeni bir cihaz geliştirdi.
Kanser hücrelerini ameliyatsız tespit eden cihaz
Sidney Teknoloji Üniversitesi öncülüğündeki bir araştırma ekibi, kanser hücrelerinin kan örneklerinden tespit edilip analiz edilmesi için yeni bir cihaz geliştirdi.



















